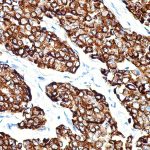
AM131
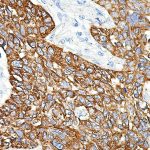
AM133

|
|---|
 Anti-Cytokeratin 7 Anti-Cytokeratin 7Buy here |
 Anti-Cytokeratin 7 Anti-Cytokeratin 7Buy here |
 Anti-Cytokeratin 7 & 8 Anti-Cytokeratin 7 & 8Buy here |
 Anti-Cytokeratin 8 Anti-Cytokeratin 8Buy here |
 Anti-Cytokeratin 8 &18 Anti-Cytokeratin 8 &18Buy here |
 Anti-Cytokeratin Cocktail Anti-Cytokeratin CocktailBuy here |
 Anti-Cytokeratin cocktail, broad spectrum Anti-Cytokeratin cocktail, broad spectrumBuy here |
|
|
 Anti-Cytokeratin HMW (Basic) Anti-Cytokeratin HMW (Basic)Buy here |
 Anti-Cytokeratin PAN, CloneAE-1/AE-3 Anti-Cytokeratin PAN, CloneAE-1/AE-3Buy here |